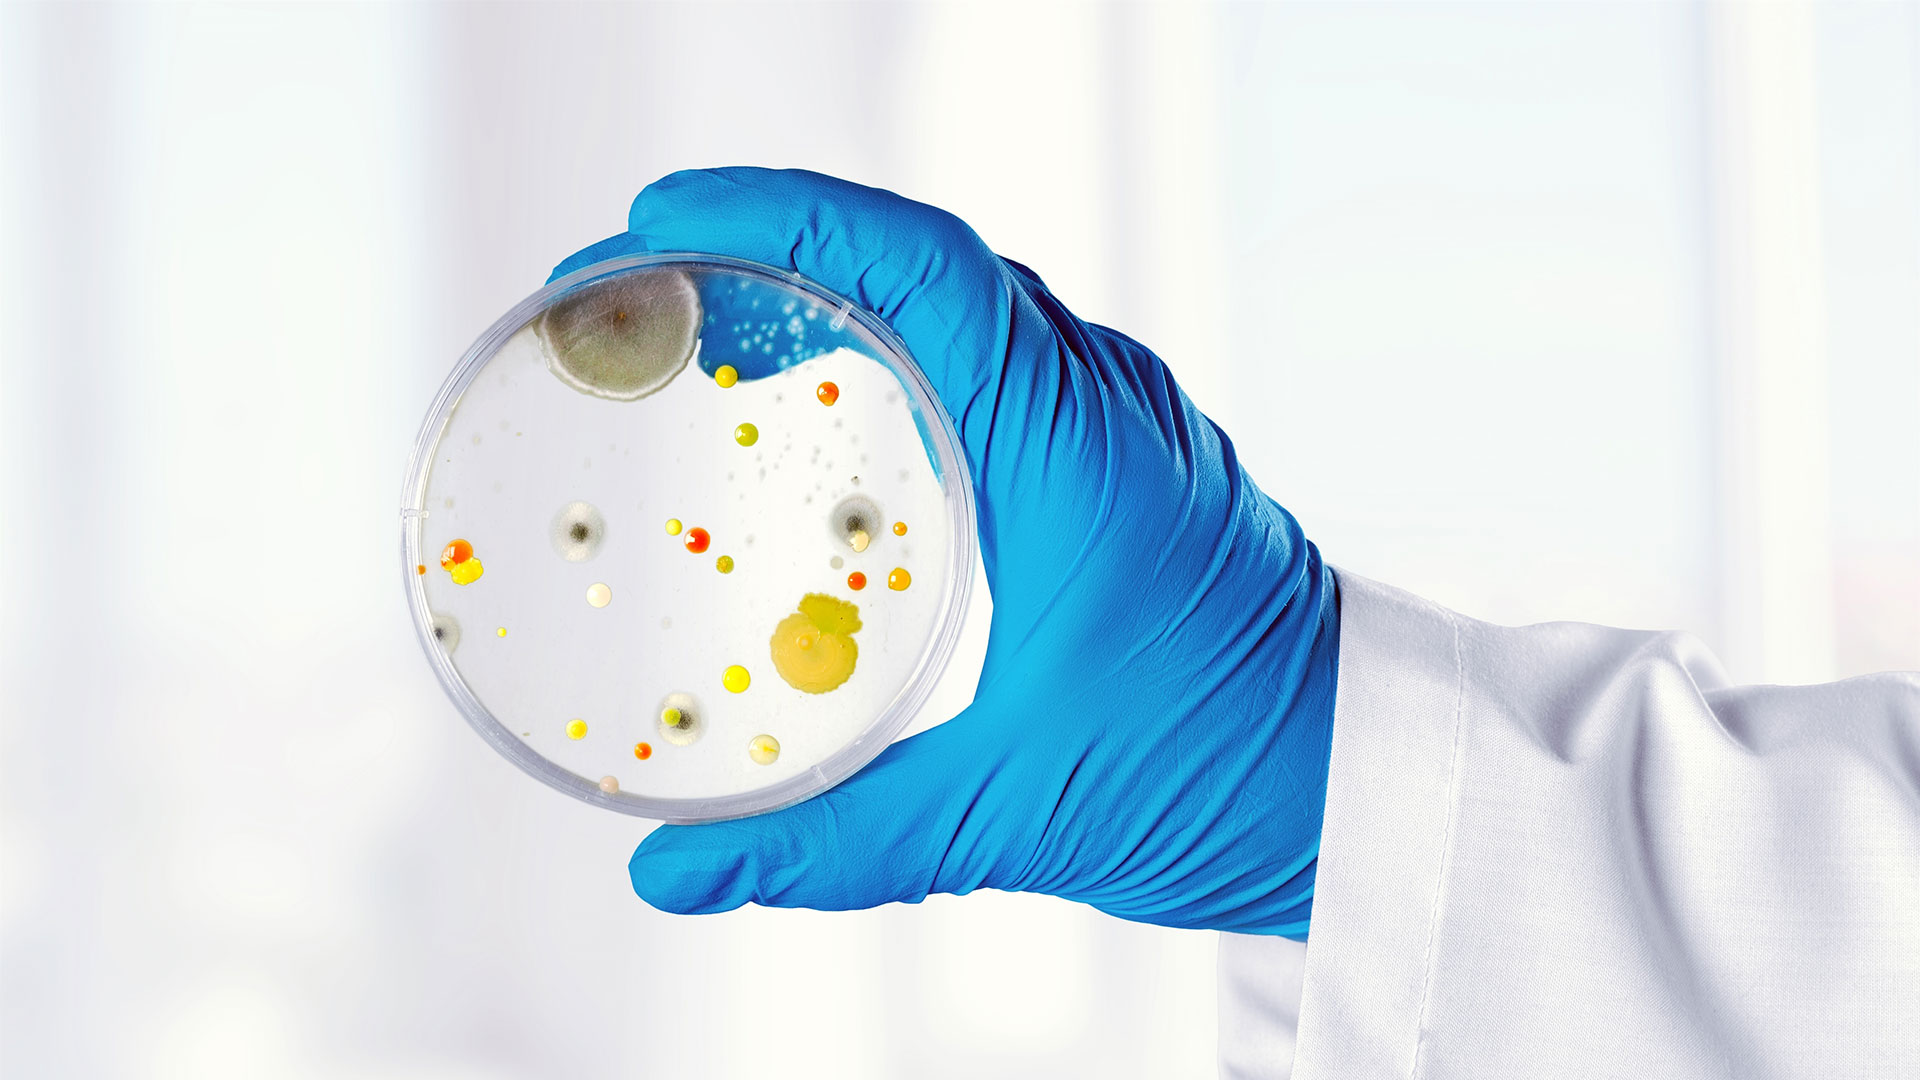

Advanced Lab Solutions Designed Around Your Health
Our advanced diagnostic laboratory, we provide accurate, timely, and reliable testing services to support healthcare providers, researchers, and patients. Equipped with state-of-the-art technology and operated by certified laboratory professionals, we ensure every sample is handled with precision and care. Our commitment to quality control and compliance with international standards guarantees dependable results you can trust.
Whether you require routine blood work, specialized pathology analysis, or preventive health screening, our laboratory services are designed to deliver fast turnaround times without compromising accuracy. We combine scientific expertise with compassionate service, ensuring a seamless experience from sample collection to result reporting.
Advanced Laboratory
Our lab is equipped with modern automated systems for high accuracy.
Comprehensive Testing
We offer a wide range of diagnostic tests to meet diverse medical needs.
Qualified Medical Experts
Our experienced professionals ensure accurate testing and patient safety.
Fast & Secure Reporting
We ensure quick turnaround time with fully secure report delivery.
Complete Diagnostic Testing Solutions
Our laboratory provides accurate and reliable diagnostic testing services using modern equipment and strict quality control standards. We are committed to delivering precise results that help doctors make informed medical decisions and support patients in managing their health effectively.
- Complete blood tests, including CBC and hematology analysis.
- Diabetes monitoring with fasting, postprandial, and HbA1c tests
- Liver and kidney function tests to detect early organ issues.
- Infection screening for dengue, malaria, typhoid, and viral diseases.
Lab Queries Answered
Q1: How long does it take to receive test results?
Turnaround times vary depending on the test type. Routine tests are often available within 24 hours, while specialized tests may take longer.
Q2: Do I need an appointment for laboratory testing?
Appointments are recommended for faster service, but walk-ins are accepted for most routine tests.
Q3: Are your laboratory services accredited?
Yes, our laboratory follows strict quality standards and complies with recognized healthcare regulations.